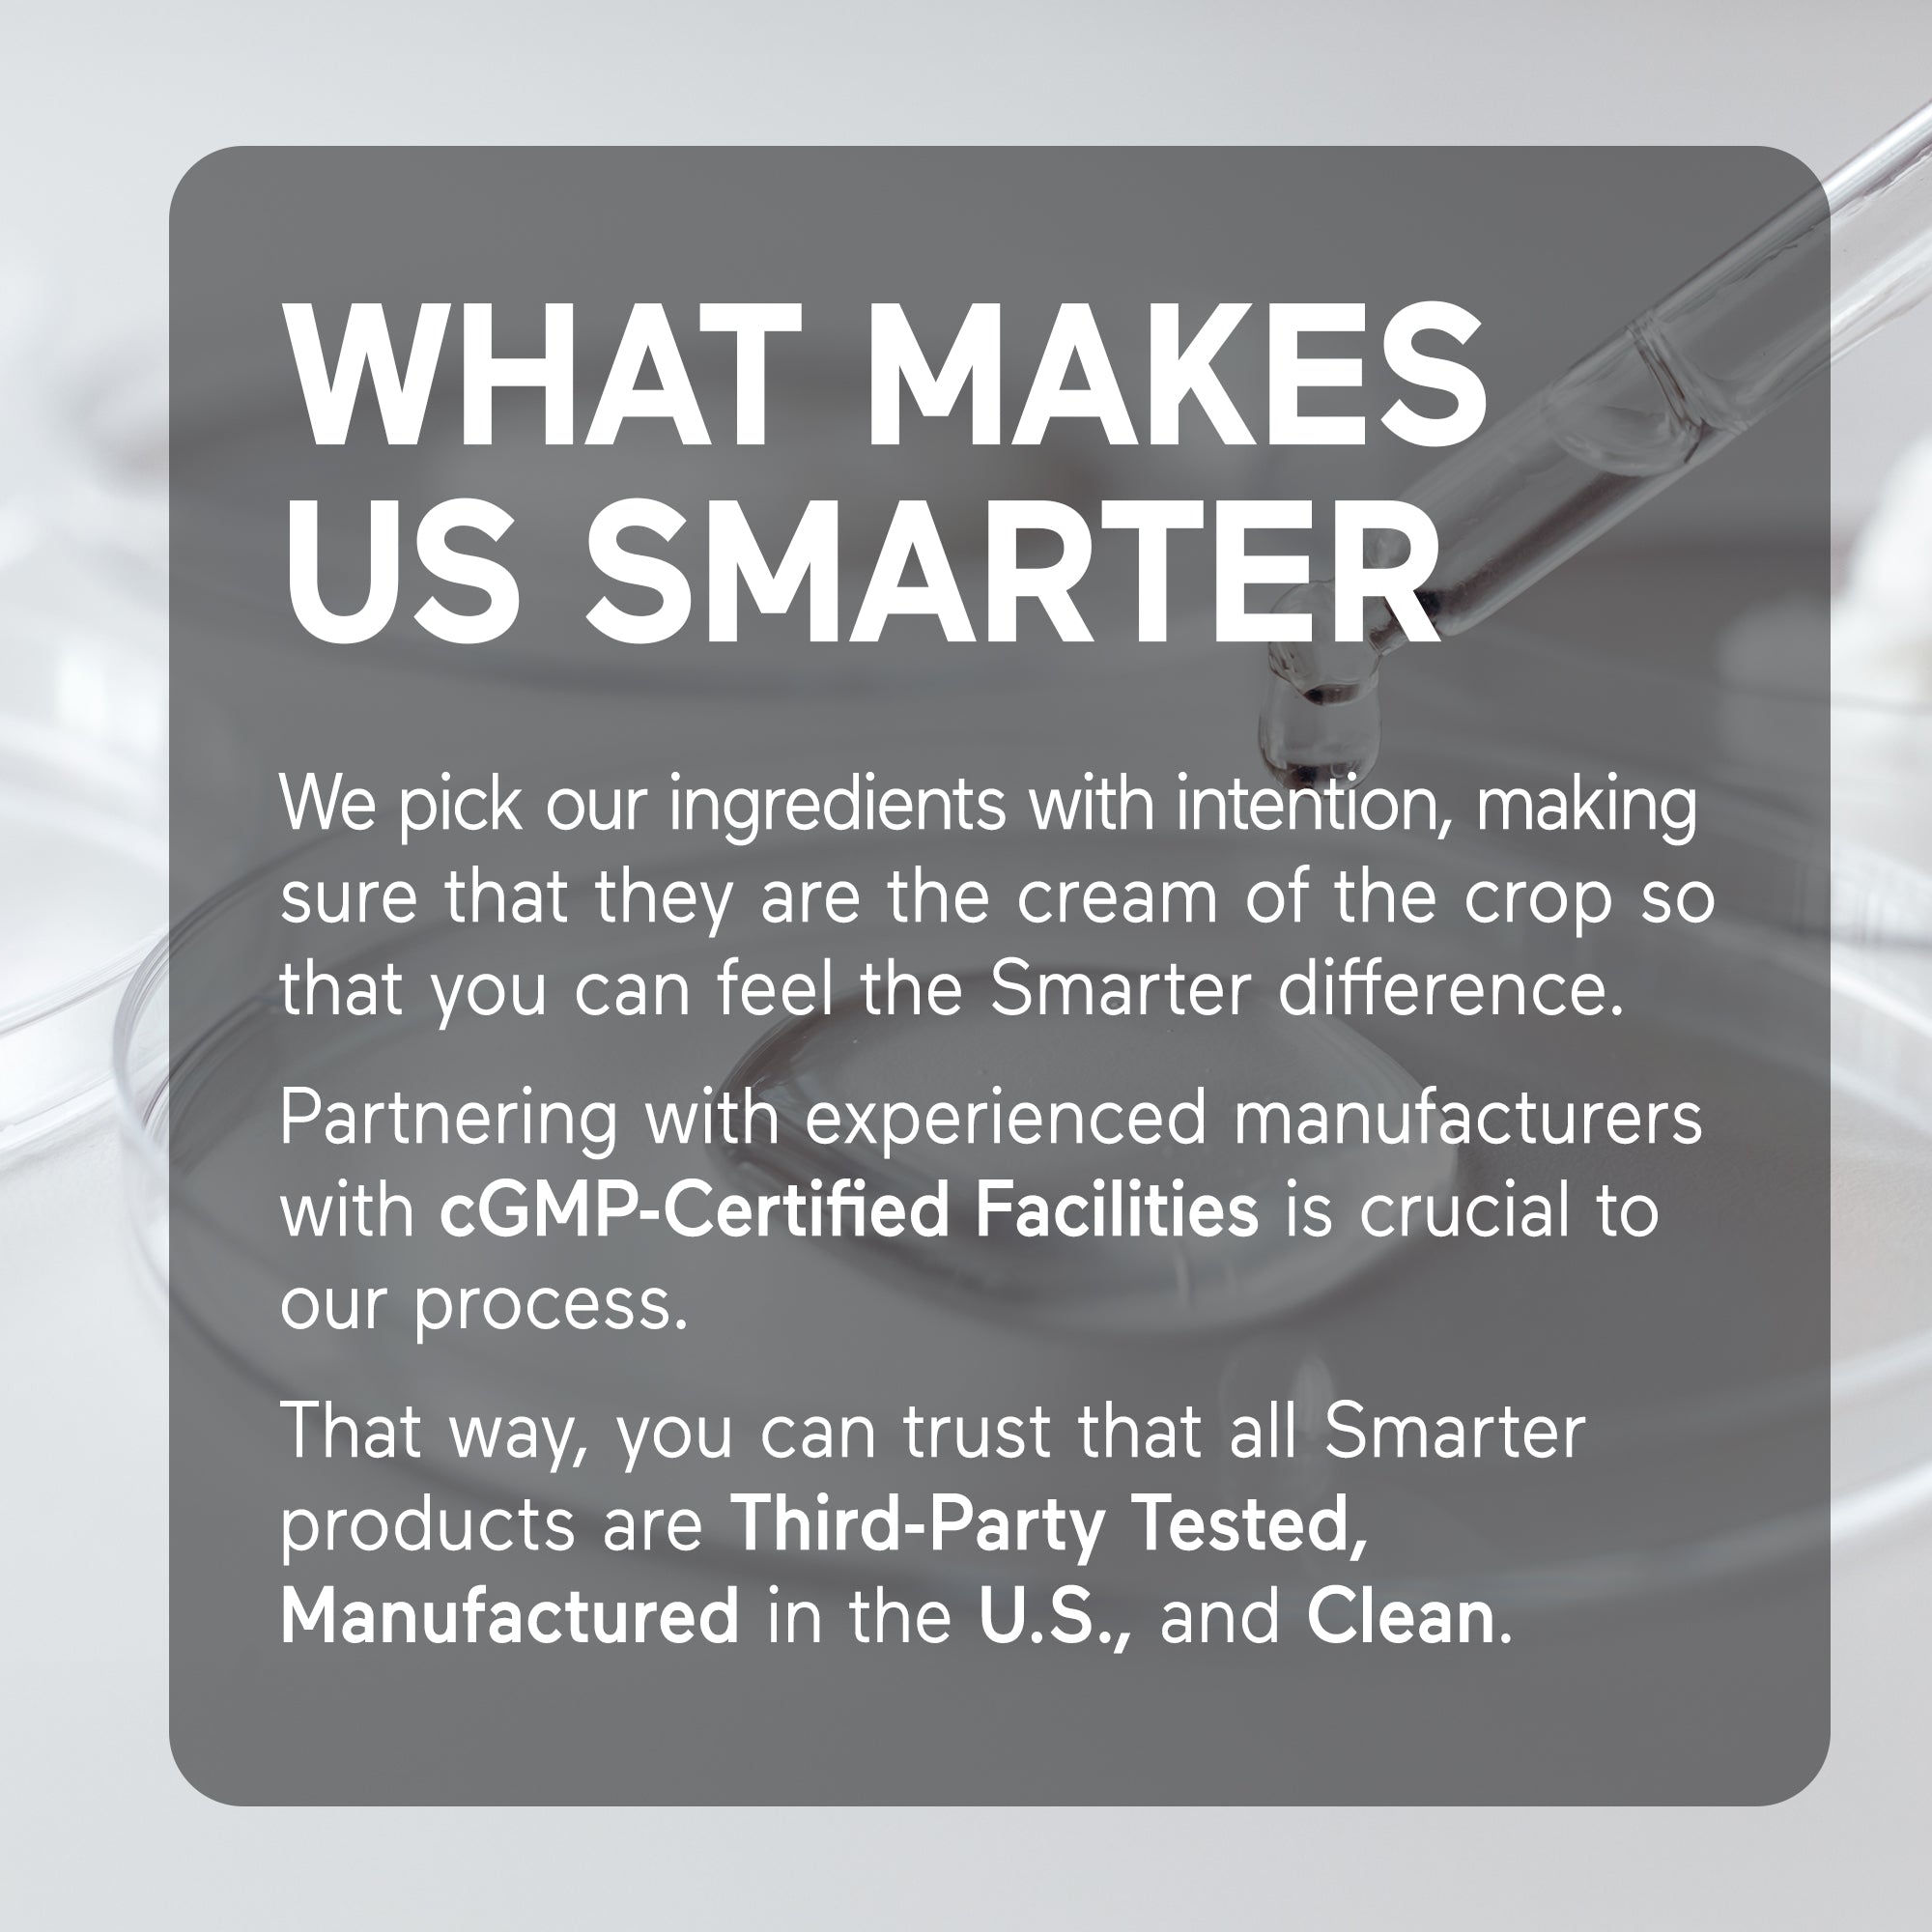
Smarter Magnesium Softgels

Smarter Magnesium Softgels
5.0Subscribe to save:
100% No Risk Money Back Guarantee
*These statements have not been evaluated by the Food and Drug Administration. This product is not intended to diagnose, treat, cure, or prevent any disease.
Product Facts
- 300 mg of natural source marine magnesium
- Vegetarian
- Avocado Oil
- AstraGin®
WARNING: Consuming this product can expose you to chemicals including lead which is known to the State of California to cause cancer and birth defects or other reproductive harm. Learn more

Naturally-Sourced Marine Magnesium
Smarter Marine Magnesium is formulated with 300mg of naturally-sourced marine magnesium, avocado oil and Astragin for ultimate absorption and bioavailability.*
What's In It?
Marine-Derived Magnesium
Avocado Oil
AstraGin®

Naturally-Sourced
Marine-Derived Magnesium
Naturally-Sourced
Marine-Derived Magnesium
Avocado Oil


Avocado Oil

AstraGin®

AstraGin®
Smarter is Clean
You deserve to trust what goes into your body, and we aim to honor that trust. Smarter Nutrition uses clean ingredients that are third-party tested, gluten free, non-GMO and manufactured in the USA.
Clean Ingredients
Non-GMO
Manufactured in the USA
Gluten Free
Third-Party Tested


